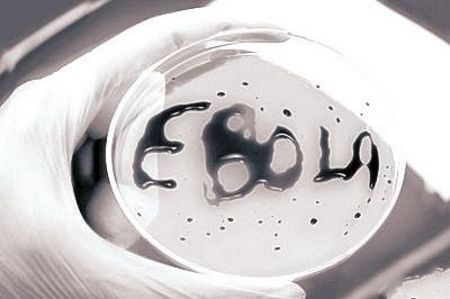

新华社里约热内卢11月21日电(记者刘隆)据巴西媒体20日报道,该国最负盛名的生物医学研究中心——布坦塔研究所日前宣布将与美国国家卫生研究院合作,以研制抗击埃博拉病毒的血清,应对在西非肆虐的埃博拉疫情。
布坦塔研究所主任若热·卡利尔介绍说,与美国国家卫生研究院签署合作协议的准备工作已接近尾声,一旦获得美方的研发授权,巴西科技机构有望在9个月内研制出抗击埃博拉病毒的血清。
卡利尔说,新血清的免疫原理是马匹对狂犬病病毒的免疫机制。一旦马对实验病毒免疫,科研人员将着重研究马的血清中是否出现大量“中和抗体”。在完成一系列毒性测试后,研究人员将用这种血清先在猴子身上进行试验,如一切顺利将随即开展临床试验。
布坦塔研究所的主要研究方向是研制疫苗、血清和生物药品,其总部位于圣保罗市。












